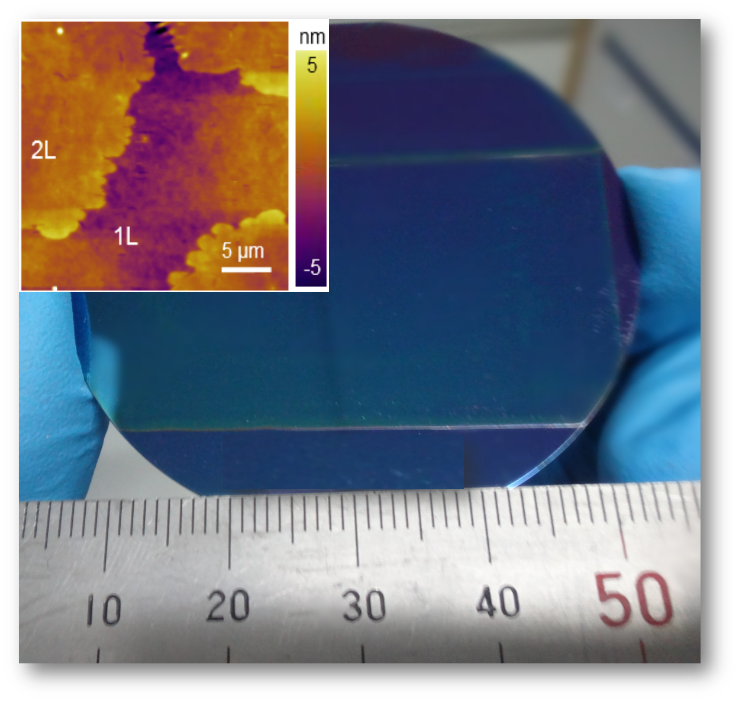

Abstract
Owing to enhanced chargetransport efficiency arising from the ultrathin nature, two-dimensional (2D)organic semiconductor single crystals (OSSCs) are emerging as a fascinatingplatform for high-performance organic field-effect transistors (OFETs).However, “coffee-ring” effect induced by an evaporation-induced convective flownear the contact line hinders the large-area growth of 2D OSSCs through a solutionprocess. Here, we develop a new strategy of suppressing the “coffee-ring”effect by using an organic semiconductor: polymer blend solution. With thehigh-viscosity polymer in the organic solution, the evaporation-induced flow isremarkably weakened, ensuring the uniform molecule spreading for the 2D growthof the OSSCs. As an example, wafer-scale growth of crystalline film consistingof few-layered 2,7-didecylbenzothienobenzothiophene (C10-BTBT)crystals was successfully accomplished via blade coating. OFETs based on thecrystalline film exhibited a maximum hole mobility up to 14.2 cm2 V-1 s-1, along with an average hole mobility as high as 9.3 cm2 V-1 s-1. Our work provides a promising strategy for thelarge-area growth of 2D OSSCs toward high-performance organic electronics.